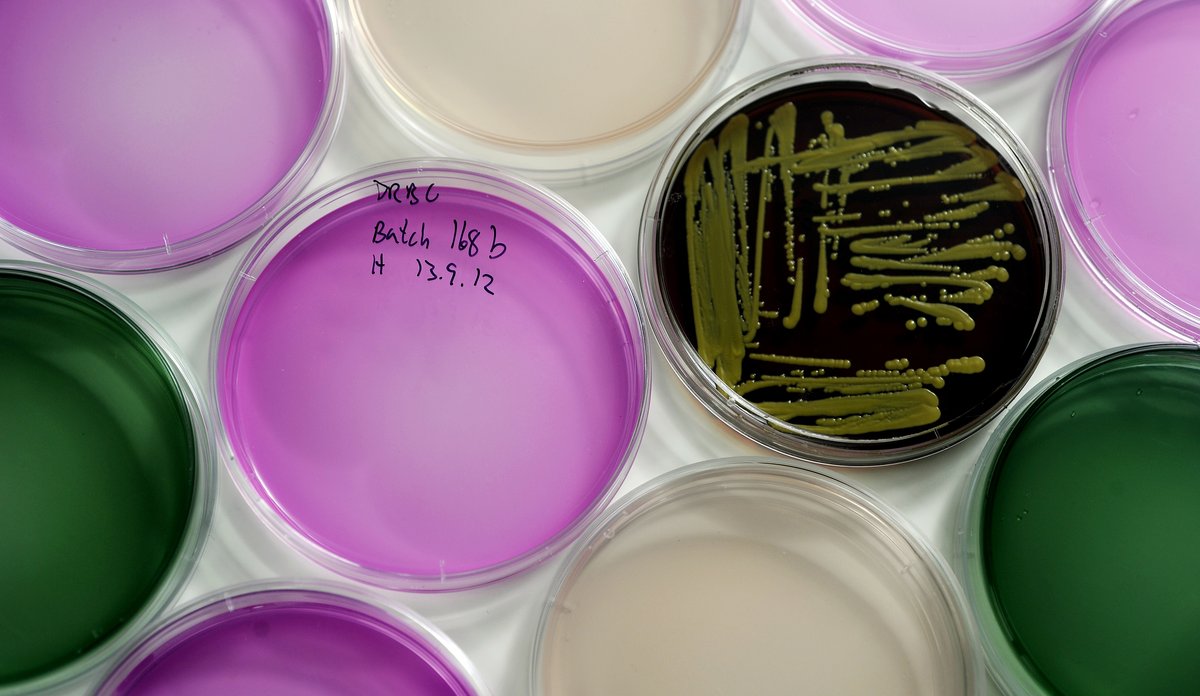
Lab helgeskodvin nifes 126

Desse bakteriane held ut i lutefisk
Visse bakteriar kan overleve i låg pH. Når pingle-bakteriane er utrydda, får dei overlevande gasse seg i fred.
Fotograf: Helge Skodvin / HavforskingsinstituttetPublisert: 17.04.2018 Oppdatert: 13.12.2022
Denne saka blei publisert i april 2018, men er fortsatt like aktuell.
Lut er det motsette av syre: ein base. Bakteriar flest likar seg midt i mellom, på nøytral pH. Derfor blei forskarane overraska då dei sjekka bakterieinnhaldet i ferdig utvatna lutefisk frå butikken.
– Vi fann ei rekke bakteriar som greier å overleve den elles harde luten. Dei er alkalifile, det vil seie at dei elskar basiske miljø, seier forskar Bjørn Tore Lunestad.
Avslørt av DNA-prøve
Lutefisk er omtala i oppskrifter tilbake til 1555 og har i dag kultstatus i Norden og delar av USA. Tradisjonsretten er laga ved å henge skrei til tørk i tre månadar, før han blir lagt i vatn og så i lut.
Luten set i gang ein prosess som minner om fordøying. Derfor blir fisken geléaktig i kjøtet, med ei karakteristisk lukt. pH-verdien til lutefisk kan vere så høg som 12 i løpet av prosessen.
Det måtte DNA-testing til for å avsløre kva bakteriar som greidde å halde ut dette.
– Det er seigingane Exiguobacterium oxidotolerans, Alishewanella tabrizica og Carnobacterium maltaromaticum. Felles for dei er at dei kan overleve og vekse i høg pH, seier Lunestad.
Kan ha mange kjelder
– Kor kjem bakteriane frå?
– Dei kan komme frå fisken sjølv, frå fiskebåten eller utstyr om bord, frå fiskarane, dei som heng fisken til tørk eller frå støv som kjem med fugl eller vêr og vind, forklarer Lunestad.
– Bakteriane overlever tørkinga, og livnar til når fisken blir lagt i vatn. Når han deretter blir luta, ryddar du dei andre bakteriane av vegen. Då får dei overlevande fritt spelerom til å formeire seg.
Trygt å hive innpå
Forskarane fann ingen tarmbakteriar eller andre sjukdomsframkallande bakteriar som Listeria, Salmonella eller Vibrio.
– Bakteriane vi fann er heldigvis ufarlege. Du kan framleis trygt hive innpå med lutefisk på julebordet, forsikrar Lunestad.
Lutefisken skulle altså kunne behalde kultstatusen sin.
Denne saka vart først publisert 17. april 2018.
Referanse
Bjørn Tore Lunestad m.fl: Microbiota of lutefisk, a Nordic traditional cod dish with a high pH. Food Control. 2018. DOI: https://doi.org/10.1016/j.foodcont.2018.03.011

